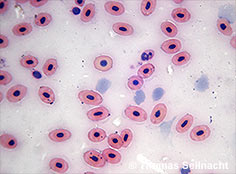
Bild vergr&ouml;&szlig;ern!

Grasfrosch
Rana temporaria L.
6 bis 11 cm, 20 bis 40 g
Familie Echte Frösche Ranidae
Klasse, Ordnung
Amphibien, Froschlurche.
Englisch: Common Frog.
Französisch: Grenouille rousse.
Lebensraum
Feuchte Wiesen, Wälder, Moore, Gärten und Gewässerränder in ganz Mitteleuropa.
Nahrung
Insekten, Würmer, Spinnen, Schnecken und kleine Wirbellose.
Beschreibung
Merkmale
Der Grasfrosch ist ein mittelgroßer Froschlurch mit gedrungenem Körperbau. Die Färbung ist variabel, meist bräunlich, oliv oder rötlich, mit dunklen Flecken. Typisch ist die dunkle Schläfenmaske, die sich vom Auge bis zum Trommelfell zieht. Die Schallblasen stülpen sich im Gegensatz zum Teichfrosch nicht nach außen. Die Haut ist glatt und feucht, die Bauchseite hell. Die Hinterbeine sind kräftig, die Schwimmhäute reichen nur bis zur Hälfte der Zehen. Ein Grasfrosch hat wie alle Froschlurche jeweils vier Finger an den Vorderextremitäten und fünf Zehen an den Hinterextremitäten. Besonderheiten des Froschblutes sind die ovale Form der roten Blutkörperchen und der vorhandene Zellkern, der bei den Säugetier-Erythrozyten fehlt. Grasfrösche können in freier Wildbahn acht bis zehn Jahre alt werden.
Der Grasfrosch ähnelt dem Moorfrosch, der jedoch eine spitzere Schnauze besitzt und zur Laichzeit bei den Männchen eine blaue Färbung annimmt. Der Springfrosch hat längere Hinterbeine und kann weiter springen. Die Grundfarbe erscheint mehr beige oder grau mit weniger kontrastierenden Zeichnungen. Vom Teichfrosch ist er durch die bräunlichere Färbung und die fehlenden Schallblasen leicht zu unterscheiden.
Lebensweise
Der Grasfrosch verbringt den Winter eingegraben im Schlamm von Teichen oder an Land in frostfreien Erdhöhlen. Im Frühjahr wandert er zu seinen Laichgewässern, wobei er eine bemerkenswerte Standorttreue zeigt. Er bevorzugt stehende oder langsam fließende Gewässer. Die Paarungszeit beginnt früh, oft schon im März. Die Weibchen legen große Laichballen mit bis zu 4000 Eiern ab, die Kaulquappen schlüpfen nach wenigen Tagen. Je nach Temperatur entwickeln sie sich innerhalb von zwei bis drei Monaten zu Jungfröschen. Grasfrösche sind überwiegend dämmerungs- und nachtaktiv, sie können bei feuchtem Wetter aber auch am Tag beobachtet werden.
Nahrungserwerb
Grasfrösche ernähren sich von Insekten, Spinnen, Würmern und Schnecken, die sie mit ihrer schnellen Zunge erbeuten. Größere Tiere können auch kleinere Amphibien fressen. Grasfrösche sitzen oft ruhig und lauern, bis die Beute in Reichweite kommt. Manche Grasfrösche beherrschen sogar das Kunststück, einen feinen Wasserstrahl auf ein sitzendes Insekt zu spritzen, so dass das Insekt fixiert wird. Die Beute wird stets komplett verschluckt.
Feinde und Gefahren
Natürliche Feinde sind Reiher, Störche, Schlangen, Fische, Füchse und Igel. Die größten Gefahren gehen vom Straßenverkehr während der Laichwanderungen, vom Verlust von Feuchtgebieten und von Pestiziden aus. In Mitteleuropa ist der Grasfrosch noch weit verbreitet und gilt als nicht gefährdet, er steht aber wie alle Amphibien unter Schutz.
Weitere Medien
Metamorphose des Grasfrosches (mit Puzzle)
Medien im Lernlabor (Kopiervorlagen, Arbeitsblätter, Quiz)
Bilderbuch Frösche (pdf)
Steckbrief zum Ausfüllen (pdf)
Merkmale der Amphibien
Übersicht europäischer Amphibien (pdf)
Fotos und Grafiken